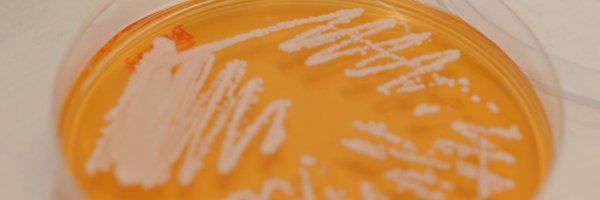
OpenCellLondon Profile Banner

Open Cell London
@OpenCellLondon
Followers
4K
Following
7K
Media
656
Statuses
8K
🧬 🧫 Building flexible, modular labs for biotech startups. See our lab consumables at https://t.co/EgZt82iWLX. Founded by @heleneopencell + @tomopencell.
London, England
Joined November 2017
🧪 We're thrilled to partner with @OpenCellLondon, an innovative company that provides fully serviced BSL2+ labs with access to specialists and equipment. Our exciting new container #labs are en route, and the scientific team is eager to embark on a journey of #discovery.
1
3
5
Join us over the next month as we plunge into the heart of marine #biodiversity #MarineBiology #OceanLife #MarineConservation #SaveOurOceans #COP28 #Biotechnology #BioTech #DNAInnovation #BiotechResearch #EnvironmentalConservation
0
0
0
🌊 Embark on an oceanic adventure with us! 🚢 Our mobile labs are en route to Tenerife, supporting @oceancensus —an initiative by The Nippon Foundation and @nektonmission —to fast-track the discovery of ocean species! 🐠🔍 https://t.co/atfl3dZrZj
1
1
6
We're about to share our next synbio for human health newsletter - be sure to subscribe to be the first to get it in your inbox! https://t.co/yga18jhNLu
0
1
1
Even without detailed knowledge of their underlying mechanisms, #machinelearning can provide data-driven insights into living systems—promising to increase the efficiency of #syntheticbiology research 🙌 Read more about machine learning in #synbio here: https://t.co/6Kooj9fEpd
0
8
18
This was one of the best podcasts I have done so far. A great book from @OxUniPress. Listen to the podcast on @NewBooksNetwork
https://t.co/2fP8YWdqTI
@OUPAcademic @OUPPhilosophy @OxfordPublicity @OWC_Oxford #philosophy #academictwitter
0
11
30
A cost-effective #OpenSource #Arduino-based #microfluidic chip carrier including temperature control and #perfusion system for long-term cell #imaging: https://t.co/ztXk5DueqG
#DIYbio #biohacking #LoC #LabOnChip #microfluidics #microscopy #OpenPharma #CitizenScience #hackerspace
0
6
6
Want to know my secrets of building a successful personal brand as an academic: https://t.co/aqRf3B3wBP
#branding #personalbrand #professional #networking #LinkedIn #phdlife #phdchat
0
1
2
Open-3DSIM: An #OpenSource three-dimensional structured #illumination #microscopy reconstruction platform: -available as #MATLAB code, #Fiji/#ImageJ plugin & executable application https://t.co/w8A3iWDzIs
#DIYbio #lab #instruments #microscope #imaging #optics #SIM #3DSIM
0
3
9
A PhD is a strange moment because while most people in your life think you're an overachiever, you feel like a total imposter who is making no progress.😅🎓 #PhD #phdchat #phdvoice #phdlife #phdstudent #AcademicChatter #AcademicTwitter #phd
2
13
100
Reductive amination cascades in cell-free and resting whole cell formats for valorization of lignin deconstruction products https://t.co/sbofPXFW9K
#biorxiv_synbio
0
1
2
We just posted V2 of our @biorxivpreprint! mRNA condensation fluidizes the cytoplasm More beautiful figures, and improved text. https://t.co/S1qZvrlzDu
biorxiv.org
The intracellular environment is packed with macromolecules of mesoscale size, and this crowded milieu significantly influences cell physiology. When exposed to stress, mRNAs released after transla...
New @bioRxiv preprint! https://t.co/rX0Xbro164
@Ying_Xie_ found that polysome collapse & mRNA condensation fluidizes the cytoplasm. This helps assembly of another membraneless stress organelle: Q-bodies! P-bodies and SGs tune the physical properties of the cytoplasm! RT plz!
0
20
89
Oh, Berlin, there was much fuzz about nothing, as it seems: Grunt not roar: Berlin lioness is likely a wild boar. What so aptly applies for working on a thesis: always fact check 🤓 DW News https://t.co/bpdWzV41gS via @YouTube #phdchat #phdlife #Berlin #sommerloch
0
1
1
New piece from @LabShih on C sequestration. "The main contributions of #plant #syntheticbiology will stem..from enabling..predictive understanding..to rationally design genotypes.. Only then will plant #SynBio be able to live up to its promise" #Numeracy
journals.plos.org
How can we attempt to engineer what we do not fully understand? This Essay argues that main contributions of plant synthetic biology in addressing climate change will stem not from delivering desired...
1
6
15
One week until @EMSLscience Summer School (July 24-28)! Register to participate in free, virtual instruction on data analysis tools for multiomics. Registration link: https://t.co/cIyElxDLsb
#EMSLSummerSchool #AcademicTwitter #phdchat #sciencetwitter #phdlife @doescience
0
4
6
#SciTwitter when I put together a scientific paper I like to storyboard it (figures and legends mostly, maybe a bit more methods detail where needed to help me follow the logic). Are there good software tools to do this? Bonus points for free or open tools!
1
1
3
Special message to Thai @igem Teams considering the MRes Synthetic Biology @UCLBiochemEng1 #SynBio #iGEM2023 MSc การวิจัยชีววิทยาสังเคราะห์จากภาควิชาวิศวกรรมชีวเคมีของ UCL จะให้ทักษะแก่คุณในการเริ่มต้นการเขียนโปรแกรมและชีววิทยาวิศวกรรมเพื่อประโยชน์ของสังคมของเรา @prdthailand
0
4
3
#SciTwitter Best ideas for a successful lab retreat? Thanks in advance for your suggestions!
1
1
2
@NikoMcCarty This paper had a big impact on me. I think what was powerful was to be able to SEE the oscillation on my computer screen. It brought home the idea that biology is a REAL THING that we can engineer. I'm getting a lot of Synbio nostalgia right now. Please keep em coming.
0
1
3
Big news in the synthetic biology world. Perfect Day dumps its consumer brand, Urgent Company, with Brave Robot ice cream and Modern Kitchen cream cheese. I guess people weren't so urgent to buy those products. #gmo #syntheticbiology
nosh.com
Perfect Day has laid off roughly 15% of its workforce as it moves to exit its consumer-facing business, The Urgent Company (TUC), in order to focus solely on its B2B ingredient sales and nth bio...
0
6
12